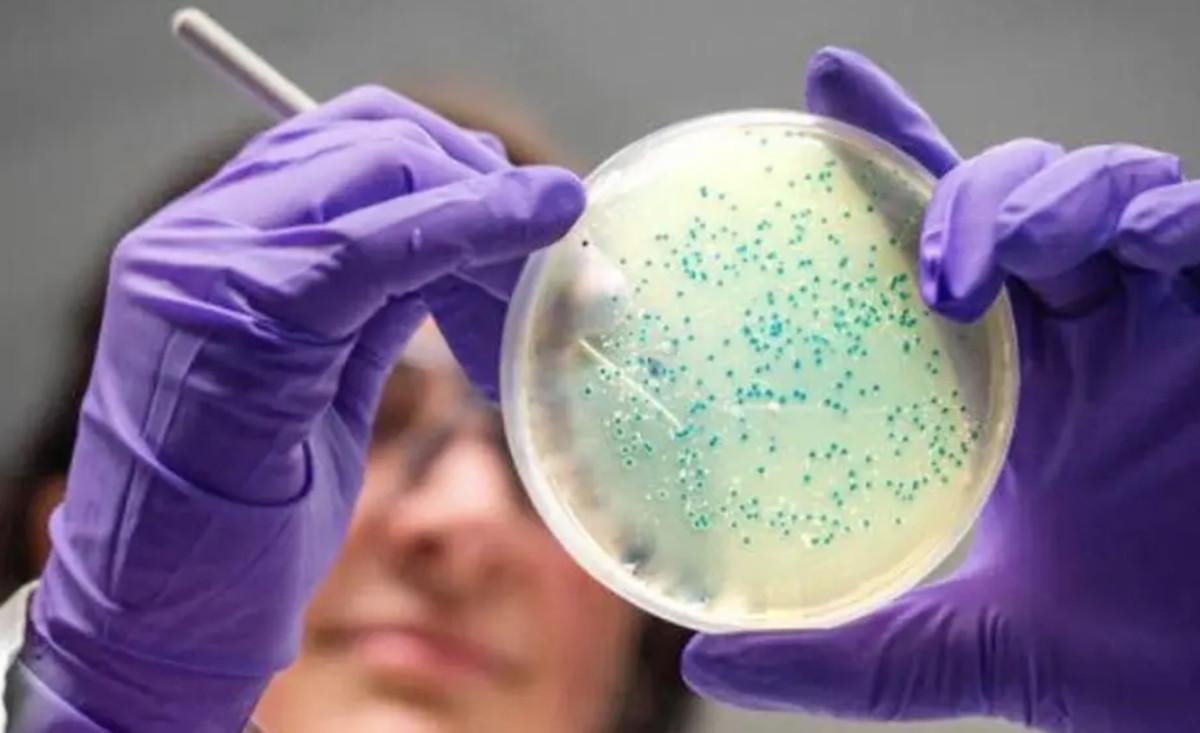

Salmonella, insanlarda ve hayvanlarda çeşitli enfeksiyonlara yol açabilen bir bakteri türüdür.
Genellikle gıda kaynaklı hastalıklara neden olan bu bakteri, ciddi sağlık sorunlarına yol açabilir.
Özellikle hijyen kurallarına dikkat edilmediğinde veya uygun şekilde pişirilmemiş gıdalar tüketildiğinde bulaşma riski artar.
Salmonella enfeksiyonları, mide-bağırsak sistemini etkileyerek ishal, karın ağrısı ve ateş gibi belirtilerle kendini gösterebilir.

Salmonella nasıl bulaşır?
Salmonella enfeksiyonları genellikle aşağıdaki yollarla bulaşır:
- Çiğ veya az pişmiş et, tavuk, yumurta ve süt ürünleri gibi gıdaların tüketilmesi.
- Salmonella ile bulaşmış suyun içilmesi veya bu suyla yıkanmış gıdaların yenilmesi.
- Özellikle sürüngenler, kuşlar ve çiftlik hayvanları Salmonella taşıyabilir.
- Enfekte bir kişinin ellerini yıkamadan hazırladığı gıdalar veya yüzeylerle temas edilmesi.
Salmonella belirtileri nelerdir?
Salmonella enfeksiyonu belirtileri genellikle enfekte gıdanın tüketilmesinden 6-72 saat sonra ortaya çıkar ve şunları içerebilir:
- Karın ağrısı
- İshal (bazen kanlı olabilir)
- Bulantı ve kusma
- Ateş
- Baş ağrısı
- Halsizlik ve yorgunluk
Hafif vakalar birkaç gün içinde kendiliğinden düzelebilir, ancak şiddetli enfeksiyonlarda tıbbi müdahale gerekebilir. Özellikle bağışıklık sistemi zayıf olan kişilerde ciddi komplikasyonlara neden olabilir.
Korunma yolları
- Gıdaları yeterince pişirin.
- Çiğ ve pişmiş gıdaları ayrı tutun.
- Eller, mutfak gereçleri ve yüzeyleri düzenli olarak temizleyin.
- Pastörize edilmemiş süt ve süt ürünlerinden kaçının.
- Güvenilir su kaynakları kullanın.
Eğer belirtiler uzun sürerse veya ciddi bir durumdan şüpheleniyorsanız bir doktora başvurmalısınız.